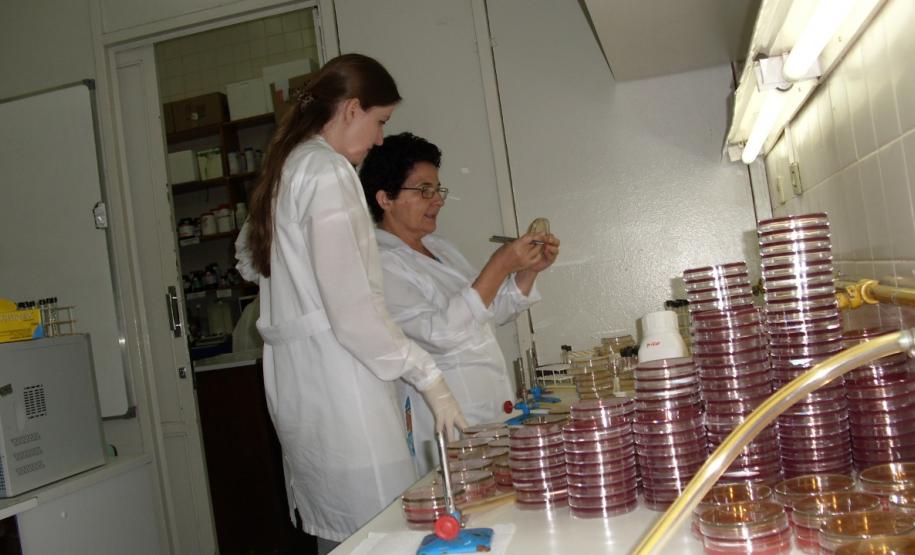
pesquisacancer2 p

Pesquisadores destacam a importância do fomento à pesquisa no combate ao câncer 07/02/2020 - 09:50
O Brasil terá 625 mil novos casos de câncer a cada ano do triênio 2020-2022. O dado divulgado, esta semana, pelo Instituto Nacional de Câncer (INCA) traz entre os principais alertas a importância do financiamento de pesquisas que contribuam para o avanço da detecção precoce e o tratamento da doença. No Paraná, a Fundação Araucária tem realizado investimentos significativos neste tipo de pesquisa.
Inúmeras campanhas destacam a importância de descobrir a doença no início, quando são grandes as chances de cura, e muitos estudos estão sendo realizados com o objetivo de buscar mecanismos que facilitem a detecção do câncer. A pesquisa “Biosensores Baseados em Ressonância de Plasmons de Superfície para Detecção Precoce de Câncer de Ovário e de Próstata”, financiada pela Fundação Araucária, obteve importantes resultados neste aspecto.
A pesquisa no diagnóstico
O coordenador do projeto, professor do Laboratório de Química de Materiais e Sensores da Universidade Estadual de Maringá (UEM), Emerson Marcelo Girotto, explica que nos estágios iniciais do câncer o corpo produz quantidades muito pequenas dos chamados marcadores da doença (biomoléculas usadas para detectar o câncer) o que dificulta que os equipamentos comuns de análise enxerguem essas substâncias.
“É nesse sentido que trabalhamos no desenvolvimento de sistemas sensoriais produzidos com ouro e outros materiais nanoestruturados que exibem algumas características diferenciadas, chamados de plasmons de superfície, que são úteis para detectar pequenas concentrações dessas substâncias relacionadas ao câncer.”
Ressaltou ainda que “o sensor conseguiu detectar uma concentração de 3 nanogramas por mililitro (3 ng/mL) do antígeno do câncer de mama. É uma quantidade muito pequena, lembrando que em pacientes cuja doença já se manifestou as quantidades encontradas no sangue variam entre 15 e 75 nanogramas por mililitro.”
De acordo com o professor Emerson Girotto, o estudo é realizado a longo prazo e deve resultar na invenção final de um equipamento ou sistema sensorial que possa detectar, sem sombra de dúvidas, um câncer em seus estágios iniciais e para isso ainda é necessário passar por testes com seres humanos.
A equipe conta com a participação do pesquisador Alexandre Brolo da Universidade de Vitória no Canadá, que possui um equipamento capaz de fabricar as nanoestruturas de ouro, utilizadas na fabricação do biosensor.
“A UEM recebeu há cerca um ano esse mesmo equipamento, por meio de um financiamento do Governo Federal, e nessa etapa de nossas investigações, estamos tentando fabricar as mesmas nanoestruturas que recebemos do Canadá. O que representa um grande avanço, pois nos torna mais independentes para a fabricação desse tipo de biosensor.”
Fomento
Somente no ano passado, a Fundação Araucária disponibilizou cerca de R$ 20 milhões em recursos para bolsas e projetos de pesquisa em todas as áreas do conhecimento. “Uma das metas deste Governo é incentivar ainda mais a pesquisa aplicada nas universidades e nos ecossistemas de inovação. Temos um potencial de pesquisadores altamente qualificado em nosso estado e a Araucária tem atuado para que estas pesquisas reflitam em qualidade de vida para a comunidade”, enfatizou o presidente da Fundação Araucária Ramiro Wahrhaftig.
O projeto coordenado pelo professor Emerson Girotto, recebeu R$ 31,7 mil durante seu desenvolvimento. Segundo o pesquisador, sem o financiamento da Fundação Araucária a pesquisa se torna inviável. “Principalmente esse tipo de pesquisa que realizamos em que são usados reagentes muito caros como anticorpos e antígenos, que chegam a custar 10 mil reais para cada uma grama”, afirma.
A opinião é compartilhada pela professora e pesquisadora sênior da pós-graduação da UEM, Terezinha Inez Estivalet Svidzinski. “Os recursos disponibilizados pela Fundação são essenciais, já que nos dão condições de laboratório, equipamentos de grande porte, insumos muito caros e possibilitam avanços importantes em nossas pesquisas.”
A pesquisa no tratamento
Para quem já recebeu o diagnóstico de câncer, lidar com os efeitos colaterais de tratamentos como a radioterapia acaba sendo um processo difícil. A professora Terezinha Svidzinski coordena a pesquisa “Avaliação do possível impacto da radiação gama, usada em tratamento de câncer de cabeça e pescoço, sobre a virulência de leveduras do gênero Candida”, que contou com o investimento de cerca de R$ 100 mil da Fundação Araucária.
A pesquisadora explica que seres humanos abrigam normalmente leveduras do gênero Candida na pele e mucosas, como colonização, portanto, sem causar danos. Entretanto, essas mesmas leveduras, em pacientes imunocomprometidos, como os submetidos à radioterapia, podem se transformar em agentes de infecções graves e fatais.
“Há poucos estudos sobre o que ocorre com esses pacientes que se tornam mais vulneráveis a estes micro-organismos. Então a nossa hipótese é que a própria radiação que é usada para combater as células cancerígenas, exerceria um papel sobre estes micro-organismos aumentando sua capacidade de se multiplicarem num organismo, provocando o câncer”, afirma.
A coordenadora do projeto destacou ainda que as leveduras foram submetidas às mesmas condições como se fosse um paciente real, recebendo toda a carga de radiação que o paciente é submetido. Lembrando que trata-se de uma pesquisa básica, por isso a equipe trabalhou com leveduras isoladas em laboratório e não do próprio paciente. “Todas as leveduras testadas sofreram o impacto desta radiação e se tornaram mais virulentas, confirmando a nossa hipótese”, disse a pesquisadora.
Segundo Terezinha Svidzinski, com esses dados, é possível que protocolos de tratamento sejam revistos, objetivando a prevenção de infecções em pacientes com câncer. “Juntas, equipes multidisciplinares poderão atuar no sentido da melhoria da qualidade de vida de pacientes em tratamento ao câncer.” A pesquisadora destacou ainda que câncer de cabeça e pescoço foram apenas o modelo para o estudo, mas que a radiação emitida para o tratamento de qualquer tumor pode atingir estas leveduras.